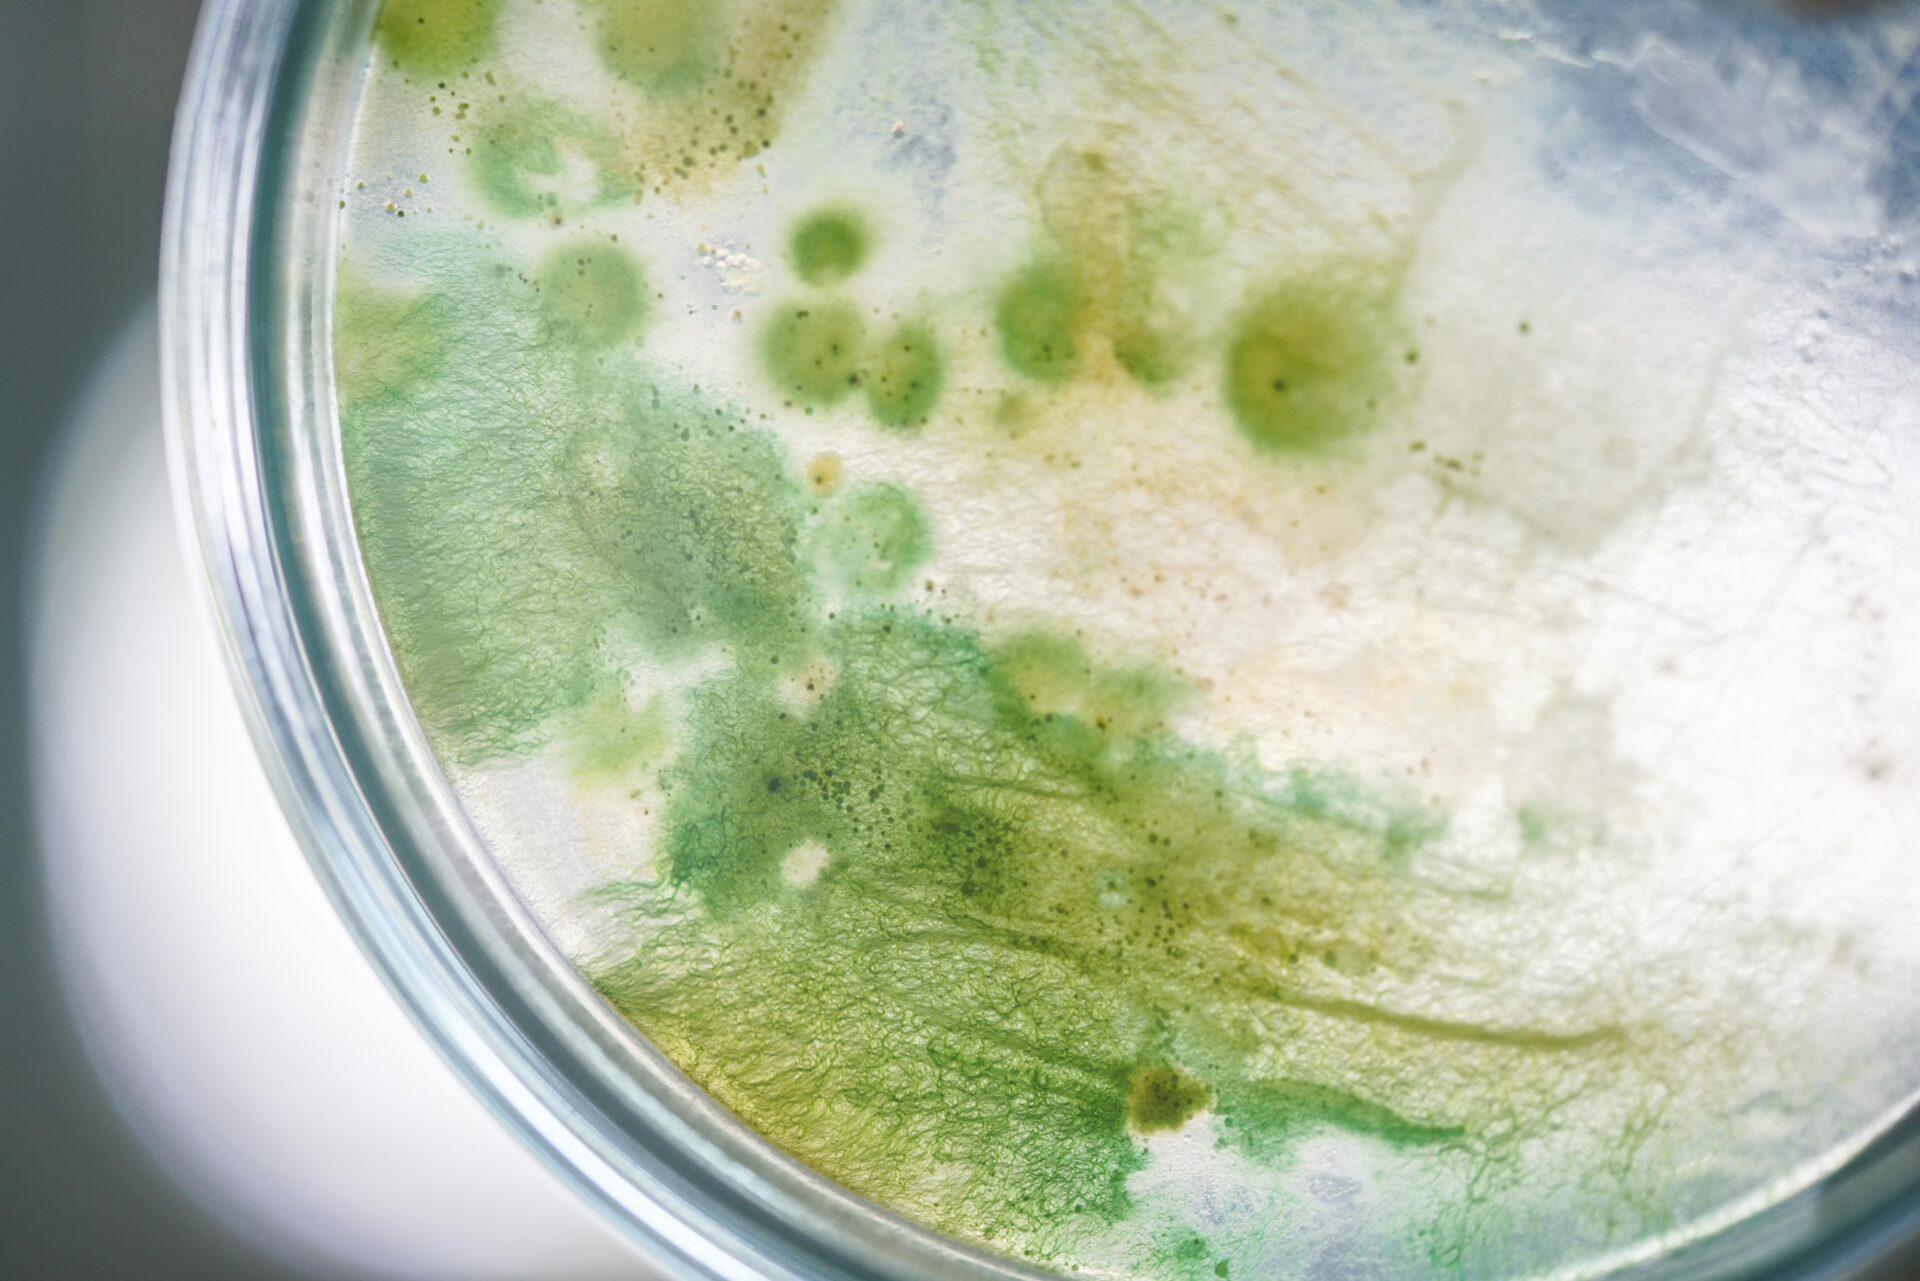

Dodane 29/07/25
Nie ma nic wspanialszego niż wakacje nad morzem. Są jednak takie dni, kiedy trzeba niestety zrezygnować z kąpieli w Bałtyku, gdyż kąpieliska są pozamykane z powodu sinic.
Pod popularną nazwą sinice kryją się cyjanobakterie, które kiedyś błędnie uważano za rośliny z uwagi na ich zdolność do fotosyntezy oraz wodne środowisko bytowania. Ich kolonie potrafią rozrosnąć się do tego stopnia, że widoczne są dla ludzi gołym okiem. Bakterie te najlepiej rozwijają się, kiedy panuje ciepła, bezwietrzna pogoda.
Od kilku lat problem ten stał się nieodłączną, choć uciążliwą, częścią wypoczynku na naszych bałtyckich plażach. Ciekawym, jest fakt, że najstarszą znaną skamieliną żyjących organizmów, której wiek określa się na około 3,5 miliarda lat, są właśnie cyjanobakterie.

Dlaczego należy unikać kontaktu z sinicami? Spośród wielu ich gatunków, które występują w Bałtyku, obecność zwłaszcza jednego jest najbardziej kłopotliwa, gdyż to on w sprzyjających warunkach namnaża się i tworzy powierzchniowe zakwity. Mowa o gatunku o łacińskiej nazwie Nodularia spumigena. Produkuje on toksynę (nodularynę), która może podrażniać układ pokarmowy, a duże jej spożycie, o które nietrudno podczas zabaw w wodzie, u osób wrażliwych może skutkować biegunką i wymiotami.
Ponadto wszystkie sinice w swojej ścianie komórkowej mają lipopolisacharydy, czyli związki, które mogą podrażniać skórę. Uczestnicy kąpieli (zwłaszcza osoby wrażliwe) mogą dostać wysypki i podrażnień skóry. Ryzyko podrażnień wzrasta wraz z ilością sinic obecnych w akwenie.

Problemu sinic nie należy więc bagatelizować. Korzystajmy z kąpielisk odpowiedzialnie. Nie narażajmy się na nieprzyjemne skutki zabawy w wodzie, które w przypadku dzieci, osób starszych i o obniżonej odporności, mogą doprowadzić do ciężkich powikłań.
Pomocna w śledzeniu zakwitu sinic w Morzu Bałtyckim może być satelitarna mapka na stronie SMHI.
Na podstawie tekstu dr Justyny Kobos z Zakładu Biotechnologii Morskiej w Instytucie Oceanografii UG